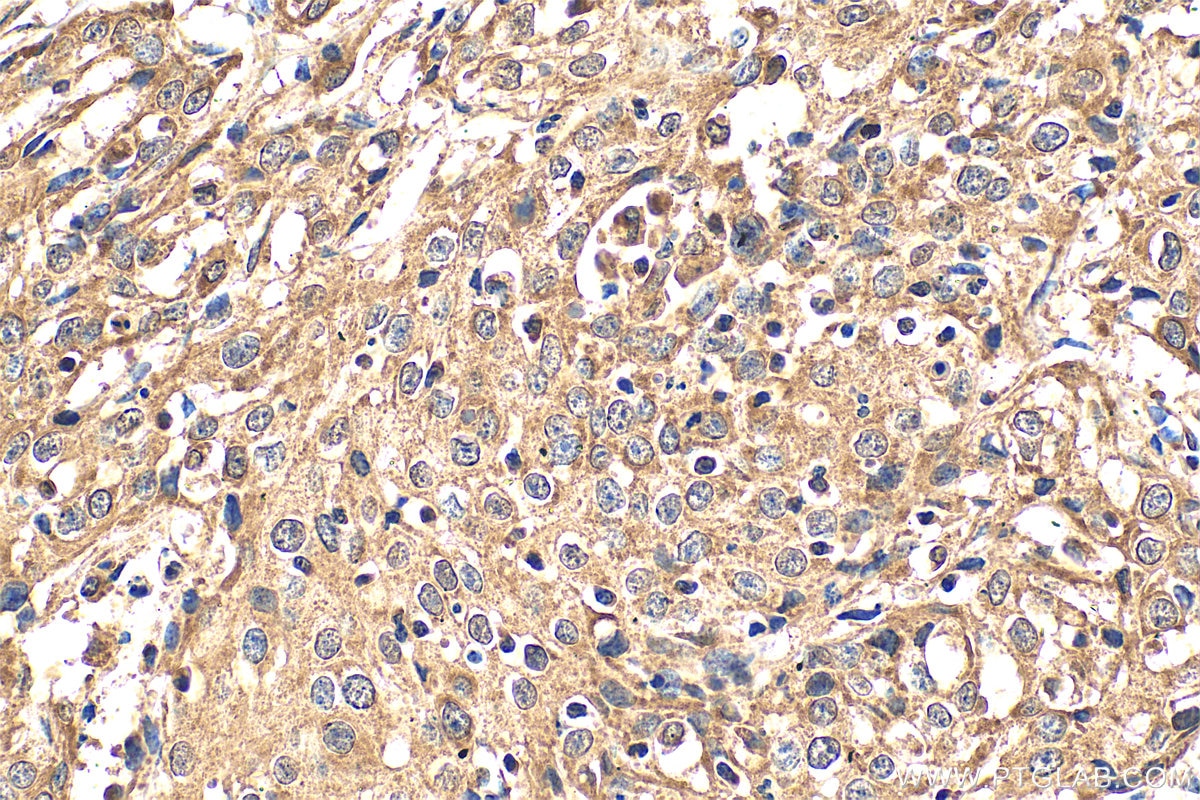
Immunohistochemical analysis of paraffin-embedded human cervical cancer tissue slide using 11115-1-AP (DDX3 antibody) at dilution of 1:200 (under 40x lens). Heat mediated antigen retrieval with Tris-EDTA buffer (pH 9.0). Immunohistochemistry (IHC) staining of human cervical cancer tissue using DDX3 Polyclonal antibody (11115-1-AP)

Tested Applications
| Positive WB detected in | HeLa cells, HepG2 cells, mouse brain tissue, mouse liver tissue, K-562 cells, C6 cells, PC-12 cells, rat brain tissue |
| Positive IP detected in | HeLa cells |
| Positive IHC detected in | human malignant melanoma tissue, human cervical cancer tissue Note: suggested antigen retrieval with TE buffer pH 9.0; (*) Alternatively, antigen retrieval may be performed with citrate buffer pH 6.0 |
| Positive IF/ICC detected in | HepG2 cells |
| Positive FC (Intra) detected in | HeLa cells |
Recommended dilution
| Application | Dilution |
|---|---|
| Western Blot (WB) | WB : 1:1000-1:8000 |
| Immunoprecipitation (IP) | IP : 0.5-4.0 ug for 1.0-3.0 mg of total protein lysate |
| Immunohistochemistry (IHC) | IHC : 1:50-1:500 |
| Immunofluorescence (IF)/ICC | IF/ICC : 1:200-1:800 |
| Flow Cytometry (FC) (INTRA) | FC (INTRA) : 0.40 ug per 10^6 cells in a 100 µl suspension |
| It is recommended that this reagent should be titrated in each testing system to obtain optimal results. | |
| Sample-dependent, Check data in validation data gallery. | |
Published Applications
| KD/KO | See 9 publications below |
| WB | See 28 publications below |
| IHC | See 5 publications below |
| IF | See 9 publications below |
| CoIP | See 6 publications below |
| RIP | See 2 publications below |
Product Information
11115-1-AP targets DDX3 in WB, IHC, IF/ICC, FC (Intra), IP, CoIP, RIP, ELISA applications and shows reactivity with human, mouse, rat samples.
| Tested Reactivity | human, mouse, rat |
| Cited Reactivity | human, mouse, rat |
| Host / Isotype | Rabbit / IgG |
| Class | Polyclonal |
| Type | Antibody |
| Immunogen |
CatNo: Ag1614 Product name: Recombinant human DDX3 protein Source: e coli.-derived, PGEX-4T Tag: GST Domain: 312-662 aa of BC011819 Sequence: DLERGCHLLVATPGRLVDMMERGKIGLDFCKYLVLDEADRMLDMGFEPQIRRIVEQDTMPPKGVRHTMMFSATFPKEIQMLARDFLDEYIFLAVGRVGSTSENITQKVVWVEESDKRSFLLDLLNATGKDSLTLVFVETKKGADSLEDFLYHEGYACTSIHGDRSQRDREEALHQFRSGKSPILVATAVAARGLDISNVKHVINFDLPSDIEEYVHRIGRTGRVGNLGLATSFFNERNINITKDLLDLLVEAKQEVPSWLENMAYEHHYKGSSRGRSKSSRFSGGFGARDYRQSSGASSSSFSSSRASSSRSGGGGHGSSRGFGGGGYGGFYNSDGYGGNYNSQGVDWWGN Predict reactive species |
| Full Name | DEAD (Asp-Glu-Ala-Asp) box polypeptide 3, X-linked |
| Calculated Molecular Weight | 73 kDa |
| Observed Molecular Weight | 73 kDa |
| GenBank Accession Number | BC011819 |
| Gene Symbol | DDX3 |
| Gene ID (NCBI) | 1654 |
| RRID | AB_10896499 |
| Conjugate | Unconjugated |
| Form | Liquid |
| Purification Method | Antigen affinity purification |
| UNIPROT ID | O00571 |
| Storage Buffer | PBS with 0.02% sodium azide and 50% glycerol, pH 7.3. |
| Storage Conditions | Store at -20°C. Stable for one year after shipment. Aliquoting is unnecessary for -20oC storage. 20ul sizes contain 0.1% BSA. |
Background Information
DDX3X, also named as DBX, DDX3 and HLP2, belongs to the DEAD box helicase family and DDX3/DED1 subfamily. It is ATP-dependent RNA helicase. DDX3X acts as a cofactor for XPO1-mediated nuclear export of incompletely spliced HIV-1 Rev RNAs. It is also involved in HIV-1 replication. DDX3X interacts specifically with hepatitis C virus core protein resulting in a change in intracellular location. 73 kDa is the target band. 60-65 kDa is some other isoform. This antibody can bind both DDX3X and DDX3Y for the close sequences.
Protocols
| Product Specific Protocols | |
|---|---|
| FC protocol for DDX3 antibody 11115-1-AP | Download protocol |
| IF protocol for DDX3 antibody 11115-1-AP | Download protocol |
| IHC protocol for DDX3 antibody 11115-1-AP | Download protocol |
| IP protocol for DDX3 antibody 11115-1-AP | Download protocol |
| WB protocol for DDX3 antibody 11115-1-AP | Download protocol |
| Standard Protocols | |
|---|---|
| Click here to view our Standard Protocols |
Publications
| Species | Application | Title |
|---|---|---|
Cell Diverse CMT2 neuropathies are linked to aberrant G3BP interactions in stress granules | ||
Neuron Pathogenic DDX3X Mutations Impair RNA Metabolism and Neurogenesis during Fetal Cortical Development. | ||
Neuron CRISPR-Cas9 Screens Identify the RNA Helicase DDX3X as a Repressor of C9ORF72 (GGGGCC)n Repeat-Associated Non-AUG Translation.
| ||
Cancer Lett NR4A1 depletion inhibits colorectal cancer progression by promoting necroptosis via the RIG-I-like receptor pathway | ||
Pharmacol Res HPV E7-drived ALKBH5 promotes cervical cancer progression by modulating m6A modification of PAK5
| ||
Ecotoxicol Environ Saf Aluminum exposure induces central nervous system impairment via activating NLRP3-medicated pyroptosis pathway |
Reviews
The reviews below have been submitted by verified Proteintech customers who received an incentive for providing their feedback.
FH Shannon (Verified Customer) (07-19-2022) | Worked well, also binds to different isoforms/protein dimers
![]() |